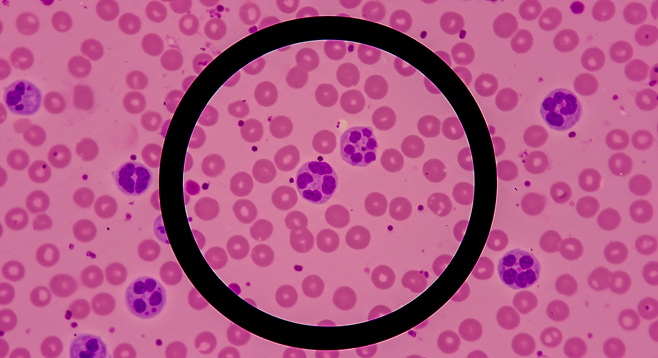

혈액암은 혈액을 구성하는 성분에 생긴 암으로, 조기 발견과 치료가 생존율을 높이는 데 중요합니다. 혈액암의 종류에는 백혈병, 악성림프종, 다발성 골수종 등이 있으며, 각각 다른 혈액 구성 요소에서 발생합니다.
혈액암의 초기 증상은 다양하게 나타날 수 있으며, 때로는 일반적인 질병과 유사해 간과하기 쉽습니다.
어떤 증상들이 혈액암을 의심해볼 수 있는 신호일까요?

주요 초기 증상
피로와 쇠약감
혈액암 환자들이 가장 흔하게 경험하는 증상 중 하나는 지속적인 피로와 쇠약감입니다. 이는 빈혈로 인해 나타나며, 충분한 휴식을 취해도 개선되지 않는 특징이 있습니다. 연구에 따르면 혈액암 환자의 약 75%가 이러한 피로감을 보고했습니다.
식은땀
특히 수면 중에 흘리는 식은땀은 혈액암의 중요한 경고 신호입니다. 혈액암 환자의 약 30%가 잘 때 식은땀을 흘린다는 보고가 있습니다. 이는 혈액암세포가 염증 물질을 방출하고 이에 면역체계가 대응하는 과정에서 발생합니다.
원인 불명의 체중 감소
특별한 이유 없이 한 달에 3kg 이상 체중이 감소한다면 혈액암을 의심해볼 수 있습니다. 2023년 연구에 따르면 혈액암 환자의 약 40%가 진단 전 상당한 체중 감소를 경험했습니다.
반복되는 감염과 발열
비정상적인 백혈구 생성으로 인해 면역 체계가 약화되어 감염에 취약해집니다. 감염이 쉽게 발생하거나 오래 지속되는 경우, 또는 원인 불명의 발열이 있다면 주의가 필요합니다.

추가적인 경고 신호
피부 변화
작은 붉은 반점(점상출혈)이 피부에 나타나거나 전신 가려움증이 발생할 수 있습니다. 혈액암세포가 피부 아래에서 염증을 일으키기 때문입니다.
림프절
종창목, 겨드랑이, 사타구니 등에서 만져지는 멍울이나 림프절 부종은 혈액암의 신호일 수 있습니다.
출혈 경향 증가
쉽게 멍이 들거나 코피, 잇몸 출혈이 자주 발생하는 것은 혈소판 감소로 인한 증상일 수 있습니다.
뼈와 관절 통증
뼈나 관절에 통증이 있거나 복부 불편감을 느끼는 것도 혈액암의 증상일 수 있습니다.

혈액암의 생존율과 치료
혈액암의 5년 생존율은 종류에 따라 다르지만, 백혈병은 60~80%, 악성림프종은 60~90%, 다발성 골수종은 1기 82%, 2기 62%, 3기 40% 정도입니다. 조기에 발견하여 치료를 시작할수록 생존율이 높아집니다.
혈액암 진단 시 항암치료, 방사선치료, 조혈모세포이식(골수이식) 등의 치료를 받게 됩니다.
주의할 점
위의 증상들이 반드시 혈액암을 의미하는 것은 아닙니다. 수면 중 식은땀은 갑상선기능항진증, 수면무호흡증, 불안장애에서도 나타날 수 있으며, 가려움증 역시 피부건조증, 아토피피부염, 당뇨병 등 다양한 원인으로 발생할 수 있습니다.
그러나 여러 증상이 함께 나타나거나 지속된다면 의사와 상담하여 적절한 검사를 받는 것이 중요합니다. 조기 발견은 치료 성공률을 높이는 핵심 요소입니다.
반딧불이 당신의 건강을 응원합니다.
Copyright © 반딧불